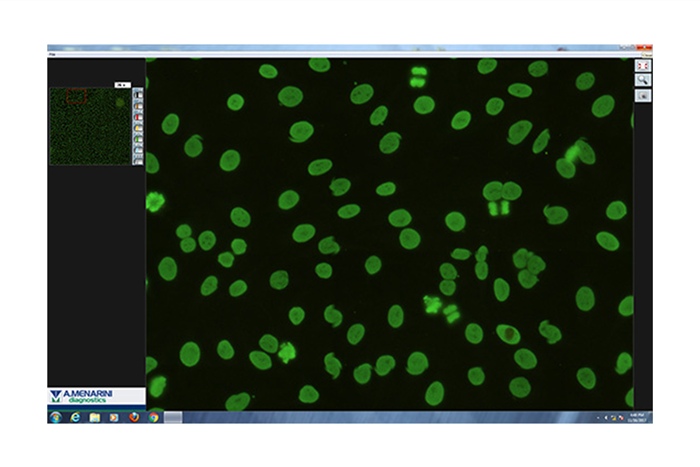

CENTRAL AND EASTERN EUROPE
information reserved for healthcare professionals
The information contained in this section is intended for the exclusive use of healthcare professionals.
Zenit HUB
The information to be found in this section is intended for the exclusive use of healthcare professionals.

- FEATURES
- MULTIMEDIA
ZENIT Hub: Centralised intelligent middleware, dedicated to the world of Autoimmunity laboratories
Zenit HUB is a powerful, user-friendly middleware that gives you immediate control of all your autoimmune sample processing (IFA, ELISA, chemiluminescence and microarray).
Seamlessly integrates instruments with your LIS:
- Manages autoimmune analysers, whether from Menarini Diagnostics or others
- Integrates with LIS systems
- Provides real-time status of all your samples
Efficiently controls workflow for IFA, ELISA, CLIA and microarray testing:
- Streamlines worklists and results to save time
- Effectively centralises all QC results and trends
Effectively processes inputs and results:
- Manages and configures IFA slides, dilutions and much more
- Creates worklists and sends them to the instruments
- Lets you review, edit and validate test results
Considerably improves laboratory activity:
- Information System tasked with receiving worklists from the LIS (HOST) of the Immunology/Autoimmunity testing Laboratory and with subsequently returning the results of the samples processed by the Menarini analysers.
- Zenit HUB software allows the integration of immunofluorescence (IIF) tests in the clinical laboratory’s computing system, avoiding time-consuming tasks such as the manual programming of the IIF analysers and the manual input of the results obtained into the Host. By simplifying the IIF input and output process enormously it avoids possible source of errors.
Zenit HUB at a glance:
- Zenit HUB connects with the LIS and with the analytical platforms of the Autoimmunity testing lab.
- Zenit HUB distributes, sends and receives the workload between the different analytical platforms.
- Zenit HUB controls, from a comfortable way for the user:
- Which instrument generates a result.
- Which user has been involved.
- With which reagents and batches the instruments have been worked. - IFI results read with readers devices connect to Zenit HUB, or manually under a microscope, through simplified data entry in the PC terminal. Zenit HUB manages the intermediate results of IFI (screening, additional tests, etc.) also.
- The results are sent back to the LIS.
- The workflow is optimized, reducing steps and manual data inputs, eliminating paper and prioritizing electronic documentations. The user can also extract quality control information, statistics and complete traceability.